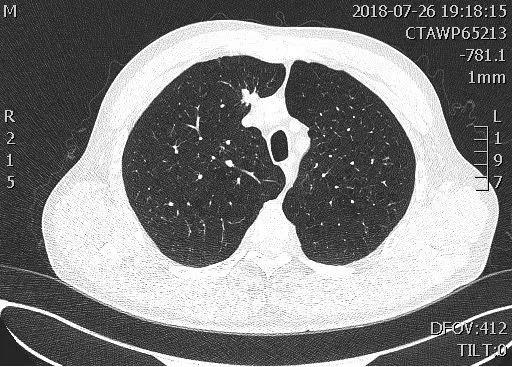

四平市中心人民医院最智能的“CT室医生”—AI人工智能肺结节筛查系统
时间:2019-06-27
人工智能(Artificial Intelligence),英文缩写为AI。它是用于研究、开发模拟、延伸和扩展人的智能理论、方法、技术及应用系统的一门新的技术科学。

四平市中心人民医院影像科是省内第一批应用该技术的医院之一,更是全四平地区唯一一家应用AI人工智能诊断系统的医院。
2018年9月,影像科引进推想人工智能辅助筛查系统,它是最智能的“CT室医生”,它可以在5秒之内读完患者的胸部CT片,并能将可疑部位进行自动标注。在我国,肺癌是发病率、死亡率最高的恶性肿瘤,在所有的恶性肿瘤当中,肺癌患者的5年生存率也是最低的,仅为17%,很多患者发现罹患肺癌时已是晚期,因此,肺癌的早发现、早治疗就显得尤为重要。要想早期发现肺癌可以进行肺结节筛查。而推想人工智能诊断系统对肺结节的发现辨识率高达99%,医生读片的结果也可以用它进行进一步核实。它与影像科诊断医生携手作战让肺结节筛查更加高效、精准。
影像科宫敬主任评价道:“推想人工智能肺结节筛查系统发现结节能力很强,还可以判断结节性质,位置因素等等,测量结节相比于人工测量更加准确,可以给医生更好的参考。”
影像科陈雷主任评价道:“有些微小结节医生用肉眼观察可能会忽略掉,但使用推想软件筛查,极大的提高了结节的检出率,提高了早期肺癌的筛查,辅助医生更加高效准确的完成胸部报告书写”。
影像科诊断医师焦桥对AI人工智能诊断系统的看法:“在针对胸膜下,心影及纵隔旁等部位的隐蔽结节人工阅片易漏诊,有了推想的辅助,有效地减少了此类结节的漏诊,且对结节的良恶性有提示。”


该病例结节位于右肺上叶纵隔旁,医生表示属于易漏诊区域,但推想AI系统给出了很清晰的标注,并提示为高危结节,后经手术证实为腺癌。
推想人工智能筛查系统已经“学习”了40多万经过专业医师标记的胸部CT结节信息,在扫描胸部CT后它会像人一样来“阅”片,与医生相结合,从而在筛查肺结节方面达到高效、精准、不漏诊的效果,更好地为患者服务。
影像科近年来在宫敬主任的带领下不断开展新技术、新项目,不断增加便民举措,提高诊断效率,精准医疗,影像先行。

影像科是四平地区规模最大、设备和技术水平最先进、配套设施最齐全的影像诊断科室。
科室现有职工42人,其中诊断医生24人,高级职称10人,具有副高级以上职称18人、硕士学历人员4人。拥有先进设备八台,包括磁共振二台(其中美国GE3.0T磁共振一台、1.5 T 磁共振一台)、德国西门子 128层及16层CT各一台、DR二台、移动DR一台、数字胃肠透视机一台。
科室以先进的设备为平台,开展新技术、新项目。主持并参加省市级科研课题十余项,“多层螺旋CT胃癌分期诊断研究”获得省自然科学基金;发表有价值学术论文一百多篇。在本地区率先开展多项技术:多层CT骨骼三维重建、心脏冠状动脉CTA造影、头颈动脉及肺动脉等血管CTA成像、泌尿系统CTU成像、急腹症CT研究、胃肠道CT三维成像、乳腺磁共振扫描、磁共振类PET成像。3.0 T 磁共振应用临床后,特有的DTI、MRS、3D神经根、动态血管成像、水脂分离、3DASL、磁敏感加权成像等技术, 提供形态及功能影像,解决了大量疑难、复杂病例的诊断。科室长期注重人才培养,全部诊断人员均多次在国内一流医院进修学习。
影像科连续多年被医院评为先进科室、特殊贡献科室,赢得了社会高度认可,成为四平地区影像专业名副其实的领军队伍。(来源:四平市中心人民医院)